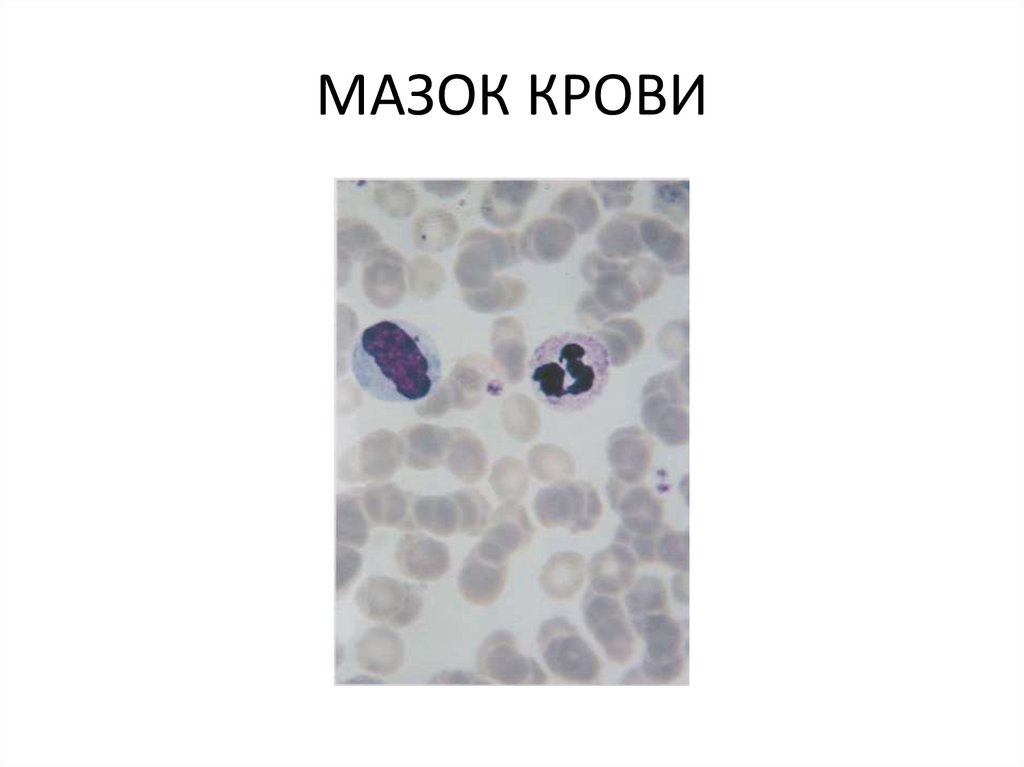

Similar presentations:
Мезотелий сальника (границы клеток, цитоплазма, ядра, стоматы)
1.
Мезотелий сальника (границыклеток, цитоплазма, ядра, стоматы).
2.
МЕЗОТЕЛИЙ.Однослойный плоскийэпителий мезодермального
происхождения.
3.
МАЗОК КРОВИ4.
МАЗОК КРОВИ5.
МАЗОК КРОВИ6.
МАЗОК КРОВИ7.
. Рыхлая волокнистаянеоформленная соединительная
ткань
8.
. Рыхлая волокнистаянеоформленная соединительная
ткань
9.
. Рыхлая волокнистаянеоформленная соединительная
ткань
10.
СУХОЖИЛИЙ В ПРОДОЛЬНОМРАЗРЕЗЕ. Плотная неоформл соед
ткань
11.
Сухожилие в продольном разрезе12.
Сухожилие в поперечном разрезе13.
Сухожилие в поперечном разрезеПлотная волокнистая оформленная
соед ткань
14.
Эластический хрящ(ушнойраковины)
15.
Эластический хрящ(ушнойраковины)
16.
Эластический хрящ(ушнойраковины)

biology
biology








